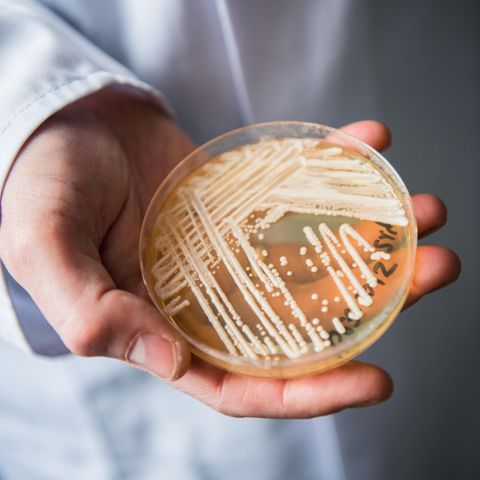

In den USA sind drei Krankenhauspatienten an einem multiresistenten Stamm des Hefepilzes Candida auris erkrankt, berichtet die US-Gesundheitsbehörde CDC. Hefen dieses Typs sind mindestens gegen ein Medikament resistent, das zur Behandlung von Pilzinfektionen eingesetzt wird. Das Besondere an den Fällen in den USA ist, dass der Pilz während der Behandlung eine weitere Resistenz entwickelte - und somit drei gängige Wirkstoffklassen nichts mehr gegen ihn ausrichten konnten.
Bei allen drei Patienten habe es sich um Menschen mit schweren Vorerkrankungen aus dem US-Bundesstaat New York gehandelt, heißt es in der CDC-Mitteilung. Die Patienten wurden alle künstlich beatmet und hatten keinen Kontakt zueinander, was eine Ansteckung trotz der örtlichen Nähe unwahrscheinlich macht. Der Hefepilz sei zunächst erfolgreich mit Arzneistoffen aus der Gruppe der Echinocadine behandelt worden, welche die Zellwand von Pilzen attackieren. Erst nach der Behandlung sei eine Resistenz auch gegen dieses Mittel festgestellt worden. Das deute darauf hin, dass die Resistenz "während der Behandlung mit den Arzneimitteln auftrat", heißt es in der Mitteilung. Zwei weitere Anti-Pilz-Mittel hatten schon vor Beginn der Therapie nichts mehr gegen den Erreger ausrichten können.
Candida auris wurde erstmals im Juli 2016 in New York nachgewiesen. Seitdem gab es Hunderte Fälle - drei davon mit dem multi-resistenten Pilz. Alle drei Erkrankten seien zwischenzeitlich verstorben, berichtet die CDC. Ob die Betroffenen als Folge der Infektion oder aufgrund der Schwere ihrer vorherigen Krankheiten starben, sei in zwei Fällen unklar. Die dritte Person sei nicht an den Folgen der Infektion verstorben.
Multi-resistente Hefepilze wie diese seien bereits in mehreren Ländern weltweit aufgetreten. Der Erreger sei "selten", berichtet die US-Gesundheitsbehörde, sein Auftreten aber dennoch "beunruhigend". Arzneimittel zur Behandlung von Pilzinfektionen sollten daher "mit Bedacht" eingesetzt werden, um die weitere Ausbildung von Resistenzen zu verhindern.
Erster Nachweis aus Japan
Erstmals wurde Candida auris im Jahr 2009 in Japan nachgewiesen - im Gehörgang einer 70-jährigen Patientin. Das erklärt auch den Namenszusatz "auris", der sich vom lateinischen Wort für "das Ohr betreffend" ableitet. Neben dem Gehörgang kann der Pilz die Harnwege, Atemwege und Wunden infizieren. Gelangt er ins Blut, kann er zu einer Blutvergiftung (Sepsis) führen. Die US-Gesundheitsbehörde CDC schätzt, dass etwa 30 bis 60 Prozent aller Fälle, bei denen der Erreger in den Körper eindringt, tödlich enden.

Weltweit kommt es immer wieder zu Infektionen mit dem Pilz, allen voran in Krankenhäusern. In Deutschland wurde Candida auris bislang nur in Einzelfällen nachgewiesen. 2015 war der Hefepilz erstmals bei zwei Patienten in Deutschland gefunden worden.
Candida auris - keine Gefahr für gesunde Menschen
Es gibt zahlreiche Arten von Hefepilzen. Sie leben natürlicherweise auf der Haut und den Schleimhäuten von Menschen. Bei gesunden Personen verursachen sie dort meist keine Probleme. Ist das Immunsystem jedoch geschwächt, können sie sich krankhaft vermehren und zum Beispiel eine Candidose (Hefepilzinfektion) auslösen.
Unter den Hefenpilzen nimmt Candida auris eine Sonderstellung ein. "Candida auris wird im Gegensatz zu allen bisher bekannten Arten häufig von Patient zu Patient übertragen und kann somit Ausbrüche in Krankenhäusern verursachen", erklärt Oliver Kurzai, Mediziner mit Schwerpunkt Pilzinfektionen in einer Mitteilung des Leibniz-Institus. Für die allgemeine Bevölkerung gehe von dem Erreger keine Gefahr aus. "Für einen gesunden Menschen stellt Candida auris keine Bedrohung dar", so Kurzai.
Als gefährdet gelten Menschen mit Vorerkrankungen. Der resistente Pilz wird meist über kontaminierte Oberflächen oder von Mensch zu Mensch weitergegeben, was auch die gehäuften Fälle von Infektionen in Krankenhäusern erklärt.
Quellen: CDC / AGES / Leibniz-Institut